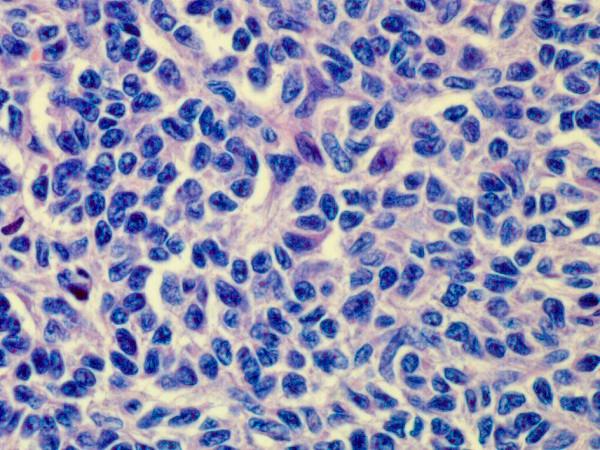
https://cdn.ncbi.nlm.nih.gov/pmc/blobs/434d/4100032/977f3f62668d/1746-1596-9-107-2.jpg

睾丸成人型颗粒细胞瘤伴异源性肉瘤成分:病例报告及文献复习。
Adult type granulosa cell tumor of the testis with a heterologous sarcomatous component: case report and review of the literature.
机构信息
Institute of Pathology, Medical University Innsbruck, Muellerstrasse 44, A-6020 Innsbruck, Austria.
出版信息
Diagn Pathol. 2014 Jun 3;9:107. doi: 10.1186/1746-1596-9-107.
UNLABELLED
Adult testicular granulosa cell tumors are rare sex cord- stromal tumors of which only 45 have been previously reported. As compared with their ovarian counterparts, these tumors may follow a more aggressive course because the proportion of malignant cases is higher. We report here a unique case of a 78-year Caucasian with a left sided adult type granulosa cell tumor with a heterologous sarcomatous tumor component. A heterologous sarcomatous component has occasionally been observed in ovarian tumors but never in testicular granulosa cell tumors. The sarcomatous component showed a higher number of mitotic figures (1/Hpf) and a marked proliferation rate (up to 50% Ki 67 positive cells) compared with the granulosa type tumor component. CD 99 and the progesterone receptor were positive in both tumor components, inhibin and calretinin only in the granulosa cells, and pancytokeratin only in the sarcomatouse one. Key words: testis - ovary - granulosa cells - sarcoma - inhibin Runing title: testicular sarcomatous granulosa tumor.
VIRTUAL SLIDES
The virtual slide(s) for this article can be found here: http://www.diagnosticpathology.diagnomx.eu/vs/6959043481207016.
未注明
成人睾丸颗粒细胞瘤是一种罕见的性索-间质肿瘤,此前仅报道了 45 例。与卵巢相应肿瘤相比,这些肿瘤的侵袭性可能更高,因为恶性病例的比例更高。我们在此报告 1 例 78 岁白人男性左侧成人型颗粒细胞瘤,伴有异源性肉瘤样肿瘤成分。异源性肉瘤样成分偶尔可见于卵巢肿瘤中,但从未见于睾丸颗粒细胞瘤中。与颗粒细胞瘤成分相比,肉瘤样成分的有丝分裂数(1/HPF)更高,增殖率更高(多达 50%Ki-67 阳性细胞)。CD99 和孕激素受体在两种肿瘤成分中均为阳性,抑制素和钙视网膜蛋白仅在颗粒细胞中阳性,而广谱细胞角蛋白仅在肉瘤样细胞中阳性。关键词:睾丸-卵巢-颗粒细胞-肉瘤-抑制素 幻灯片编号:本文的虚拟幻灯片可以在此处找到:http://www.diagnosticpathology.diagnomx.eu/vs/6959043481207016.